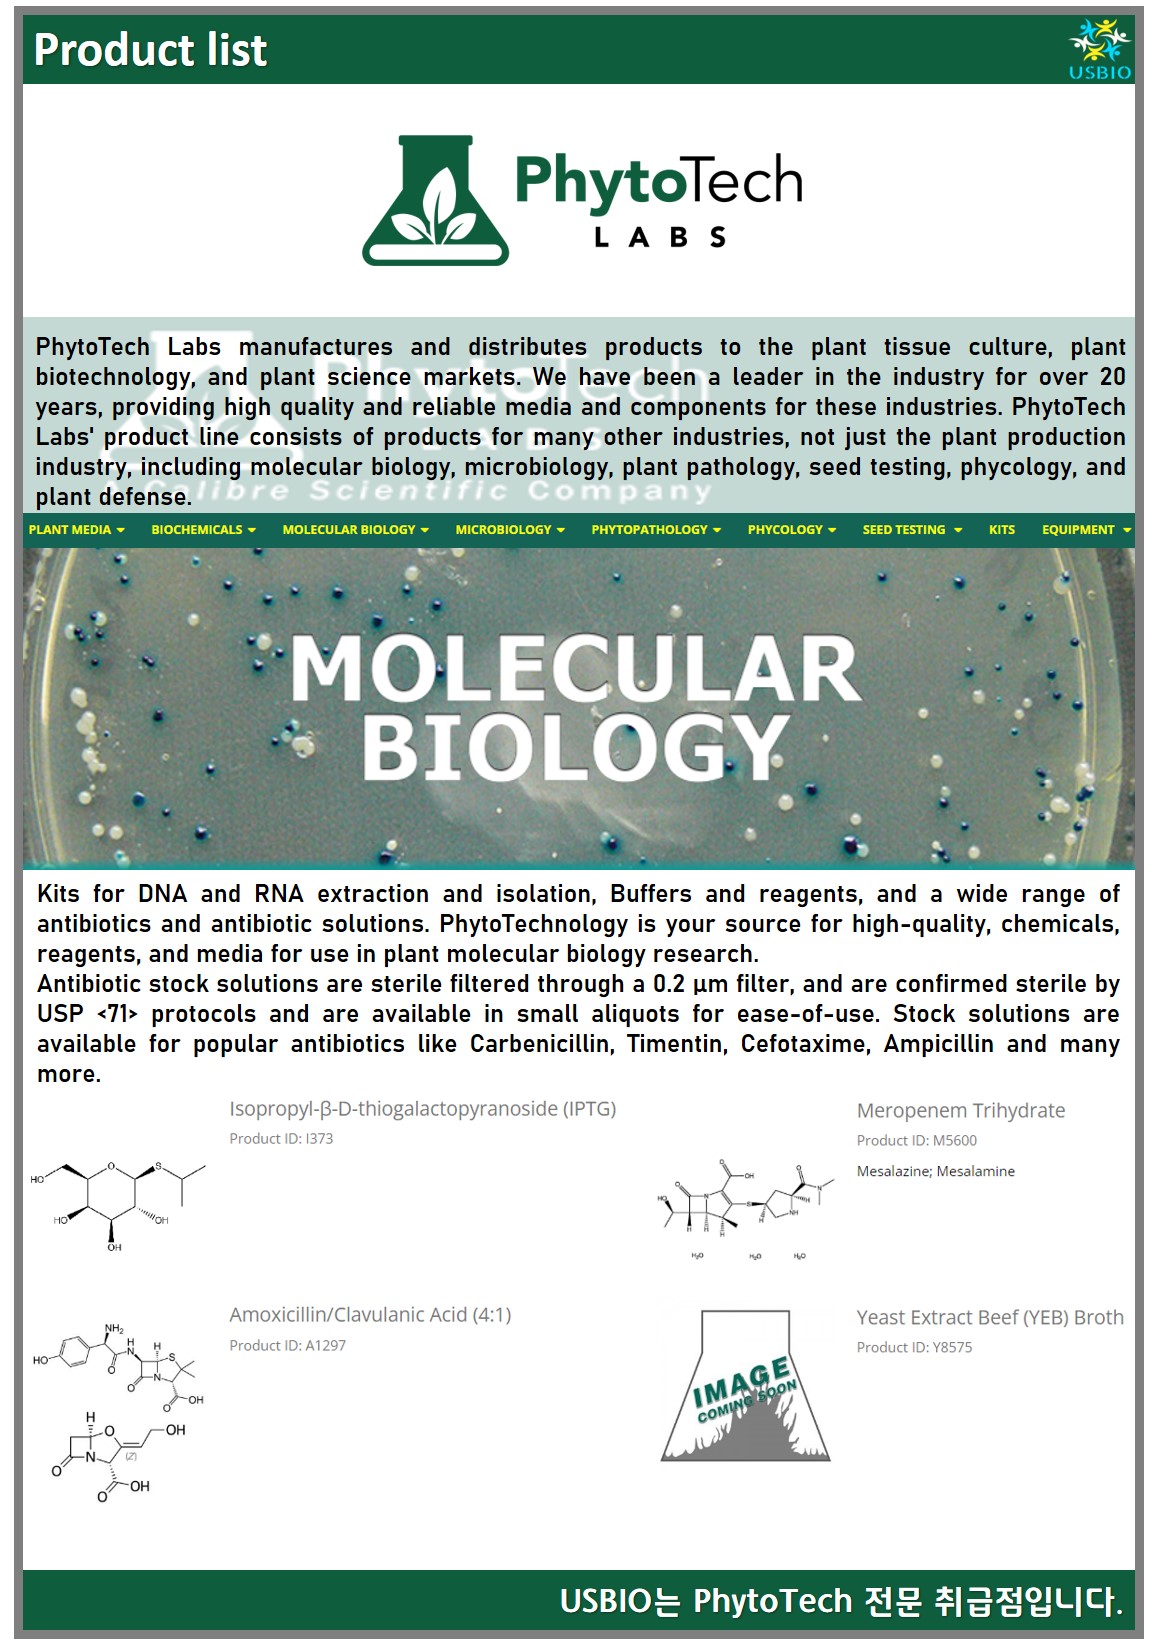

다수의 대리점을 보유하고 있는 어스바이오는 PhytoTech Labs 공식대리점 관련 업무대행/수입 전문 취급점입니다.
PhytoTech Labs는 식물 조직 배양, 식물 생명 공학 및 식물 과학 시장에 제품을 제조 및 유통하고 있는 생명 공학 회사로 식물 과학 산업을 위한 고품질 영양 배지 및 생화학 물질 유통 제조 분야의 글로벌 리더입니다. PhytoTech Labs는 실험실 장비 및 용품, 항생제, 식물 성장 조절제 및 식물 호르몬, 겔 화제 및 탄수화물을 식물 조직 배양, 생리학, 미생물학 및 식물 병리학 뿐만 아니라 종자 테스트 및 기타 관련 과학을 목적으로 연구 실험실 및 상업 기관 모두에서 사용할 수 있는 제품을 공급하고 있으며 20년 이상 업계를 선도해 오면서 고품질의 신뢰할 수 있는 미디어와 구성 요소를 제공하고 있습니다.

#PhytoTech